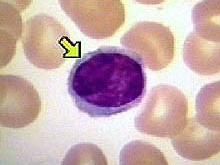
淋巴細胞計數 淋巴細胞計數

正常範圍
淋巴細胞0.2~0.4(20%~40%)。
參考範圍:0.8-4,單位:10e9/L。
臨床意義
增多:見於病毒感染、結核病、百日咳、傳染性單核細胞增多症、傳染性淋巴細胞增多症、淋巴細胞白血病、淋巴肉瘤。
減低:見於細胞免疫缺陷病、某些傳染病的急性期、放射病、套用腎上腺皮質激素、抗淋巴細胞球蛋白治療、淋巴細胞減少症、免疫缺陷病、丙種球蛋白缺乏症等等。
淋巴細胞計數<1500常提示營養不良。
淋巴細胞計數是指對不同類型的白細胞分別計數並計算百分比。
正常範圍
淋巴細胞0.2~0.4(20%~40%)。
參考範圍:0.8-4,單位:10e9/L。
臨床意義
增多:見於病毒感染、結核病、百日咳、傳染性單核細胞增多症、傳染性淋巴細胞增多症、淋巴細胞白血病、淋巴肉瘤。
減低:見於細胞免疫缺陷病、某些傳染病的急性期、放射病、套用腎上腺皮質激素、抗淋巴細胞球蛋白治療、淋巴細胞減少症、免疫缺陷病、丙種球蛋白缺乏症等等。
淋巴細胞計數<1500常提示營養不良。
淋巴細胞減少:主要見於套用腎上腺皮質激素、烷化劑、抗淋巴細胞球蛋白等治療及長期接觸放射線、免疫缺陷病、丙種球蛋白缺陷症等。
急性淋巴細胞白血病(ALL)是急性白血病的一種類型。ALL是兒童最常見的白血病類型,成人發病率較低,占成人急性白血病的15%~25%,老年人患病率更低,...
疾病描述 症狀體徵 疾病病因 診斷檢查 鑑別診斷急性淋巴細胞白血病(ALL)是急性白血病的一種類型。ALL是兒童最常見的白血病類型,成人發病率較低,占成人急性白血病的15%~25%,老年人患病率更低,...
臨床表現 發病原因 診斷檢查 鑑別診斷 併發症T淋巴細胞來源於骨髓的多能幹細胞(胚胎期則來源於卵黃囊和肝)。在人體胚胎期和初生期,骨髓中的一部分多能幹細胞或前T細胞遷移到胸腺內,在胸腺激素的誘導下分...
簡介 發育和分化 分類 表面標誌 生物學功能淋巴細胞比率(Lymphocyte ratio),外周血液塗片,經wright染色後觀察其形態,白細胞可分為5種類型,即中性粒細胞、嗜酸性粒細胞、嗜鹼性...
絕對計數是按實際檢測結果計數;相對計數是通過實際檢測結果與理論值按百分比做的結果。
概念 計數與分析 方法廣義來講白細胞可以分為粒細胞、單核細胞、淋巴細胞。凡是白細胞系統的細胞發生惡變稱為白血病細胞,而白細胞細胞占據了造血器官,蔓延到外周血則為白血病。
早期症狀 診斷: 檢查方法 治療要點 預後